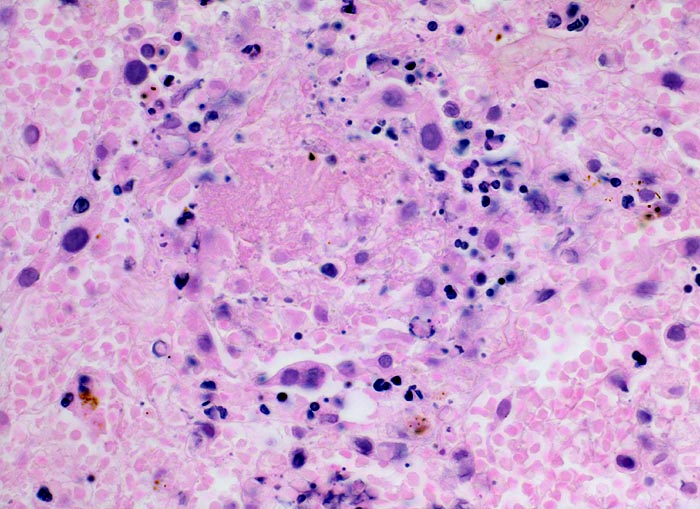

PathoPic – image database / PathoPic ID 3565 - hämorrhagischer Lungeninfarkt
de
Diagnose
hämorrhagischer Lungeninfarkt
Diagnose Gruppe
vaskulär / Durchblutungsstörung
Topographie
Lunge
Topographie Gruppe
Lunge, Mediastinum mit Thymus
Beschreibung
Klinik
Tiefe Beinvenenthrombosen bei metastasierendem Prostatakarzinom. Koronare Herzkrankheit.
Bilder Typ
Histologie
Vergrösserung
400
Alter
86
Geschlecht
männlich
Datum
Ersteintrag: 17.12.2001
Update: 04.02.2024